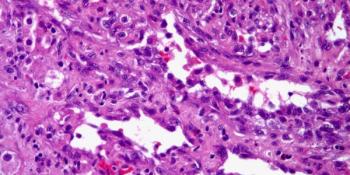

A 47-year-old man presents with a lip mass. A biopsy is performed. What is your diagnosis?

Your AI-Trained Oncology Knowledge Connection!


A 47-year-old man presents with a lip mass. A biopsy is performed. What is your diagnosis?

A 12-year-old boy presents with a mass on the right side of the neck. What is your diagnosis?

A 27-year-old man presents with a mass in the right calf. A biopsy is performed. What is your diagnosis?

A 44-year-old woman is found to have a large mass in the anterior mediastinum. What is your diagnosis?

A 54-year-old man presents with diffuse peritoneal thickening. What is your diagnosis?

A 43-year-old woman presents with enlargement of the thyroid gland. What is your diagnosis?

A 37-year-old man presents with a mass in the abdominal area. What is your diagnosis?

A 35-year-old man presents with a mass in the right arm. What is your diagnosis?

A 19-year-old man presents with a mass in the right neck. What is your diagnosis?

A 27-year-old man presents with a mass in the right testicle. A biopsy is performed. What is your diagnosis?

A 47-year-old man presents with a mass in the right thigh. A biopsy is performed. What is your diagnosis?

A 13-year-old boy presents with loss of vision in his right eye and is described as having a pink eye. What is your diagnosis?

A 48-year-old man presents with chest pain. Imaging shows the presence of a chest wall mass. What is your diagnosis?

A 58-year-old man presents with a mass in the right side of the neck. What is your diagnosis?

A 17-year-old boy presents with respiratory difficulty. A mass in the upper respiratory tract is identified. What is your diagnosis?

A 35-year-old woman presents with chest pain. Imaging shows a large anterior mediastinal mass. What is your diagnosis?

A 3-month-old child presents with seizures. On imaging a heart mass is observed. What is your diagnosis?

A 65-year-old man presents with heart failure. A biopsy of the heart is obtained. What is your diagnosis?

A 47-year-old man presents with chest pain. Imaging reveals the presence of a large anterior mediastinal mass. What is your diagnosis?

A 15-year-old boy is found to have a liver mass. A biopsy is performed. What is your diagnosis?

A 69-year-old man presents with weight loss and malaise. Imaging shows an ill-defined mass in the pancreas. What is your diagnosis?

A 47-year-old man presents with epigastric pain. Imaging shows a discrete thickening in the pancreas. What is your diagnosis?

A 54-year-old man with symptoms of esophageal reflux is found to have a small nodule in the esophagus. What is your diagnosis?

A 27-year-old man presents with axillary lymphadenopathy. What is your diagnosis?

A 47-year-old woman is found to have a mass in the left atrium of her heart. What is your diagnosis?

A 54-year-old man is found to have a nasopharyngeal mass. What is your diagnosis?
A 72-year-old woman presents with a right buttock mass. What is your diagnosis?

A 48-year-old man presented with an anterior mediastinal mass, and a biopsy is performed. What is your diagnosis?

A 34-year-old man presents with a purplish lesion of the right leg. Surgical resection is performed. What is your diagnosis?

A 1-year-old child presents with leukocoria secondary to retinal detachment. Enucleation of the eye is performed. What is your diagnosis?